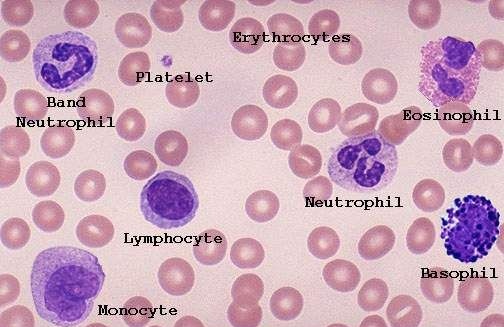

🔴معلومه بالبلدي :الباند سل تجي على شكل حذاء الحصان، وجودها يعني أن فيه نيتروفيل غير ناضجه،
اذا فيه إلتهاب او عدوى تجي رسائل للـ Bone Marrow نحتاج نيتروفيل نحتاج نيتروفيل عشان نقاوم فـ يقوم يدف (يطلق) نيتروفيل غير مكتمله.. يجي شكلها زي حذاء الحصان او شكل حرف J او حتى تجيك مجزأه.
اذا فيه إلتهاب او عدوى تجي رسائل للـ Bone Marrow نحتاج نيتروفيل نحتاج نيتروفيل عشان نقاوم فـ يقوم يدف (يطلق) نيتروفيل غير مكتمله.. يجي شكلها زي حذاء الحصان او شكل حرف J او حتى تجيك مجزأه.
جاري تحميل الاقتراحات...